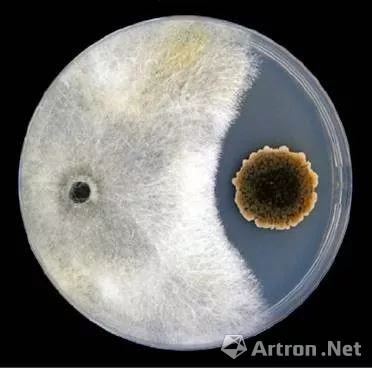
LXNIBq66Fbw6oJ0IFb0VnIhKdgCdpH8nbFYnAvES.jpeg

12月12日,携手西班牙驻华使馆,展览“Fotciencia 15”在上海塞万提斯图书馆-西班牙驻沪领馆文化处开幕,西班牙驻华公使豪尔赫·罗密欧阁下出席了开幕式。该展览继北京,广州,成都巡展后抵达上海,将持续到2020年2月29日。
Fotciencia 15 是第十五届西班牙科学摄影大赛,由西班牙高等科学研究委员会(CSIC)和西班牙科学和技术基金会(FECYT)主办、Jesús Serra基金会大力支持,目的是将科学技术与摄影这种视觉艺术相结合,从而使科学在大众当中更好地传播。
在第十五届科学摄影大赛作品展览中集合了多届FOTCIENCIA获奖科学家的作品。从显微镜下的景观到肉眼可见的事物,这些科学家眼中的景象将向我们展示超越现实的美,这些神奇的图像也将使我们沉浸在一个奇妙的微观世界中。

Morir para seguir viviendo
为生而死
Miguel Simón Moya
Edición: FOTCIENCIA 15

Cannoli, la tortuga oceanógrafa
海龟坎诺里:一只海洋学家
Miquel Gomila
Edición: FOTCIENCIA 15
Competencia fúngica
真菌的竞争
Rachel Serrano
Edición: FOTCIENCIA 15
物理,化学,地质学和其他生物学仿佛与我们很遥远,但我们通过捕捉的画面能感受到科学现象的美妙,艺术创作是将观众与科学连在一起的桥梁。
如果你喜欢科学, 这种以照片形式接近科学的方式会令你耳目一新。你对科学不感兴趣?我们向你保证, 这次展览让你不再与科学形同陌路。

Nevada invernal
冬天的雪
Fernando Gómez Aguado
COAUTORÍA María Teresa Corcuera Pindado
Edición: FOTCIENCIA 15
本周四19:00在展览 Fotciencia15开幕式我们不见不散!开幕式后现场还将品尝到法兰克西班牙酒庄提供的顶级葡萄酒。如果你不能来也没关系, 该展览将在上海塞万提斯图书馆展出至2020年2月29日。快来趁本次展览享受科学吧!
